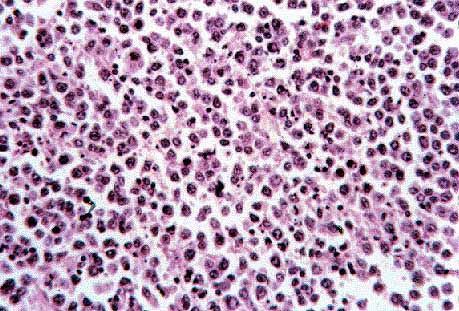
figura 6

Póster
Nş 064
Póster |
B.Báez, Rafael Camacho, Jl. Afonso, C. Muńoz*, C. Santana
 |
| Figura 1. Dilatación de los ventriculos cererbrales laterales. No se observa masa tumoral. |
 |
| Figura 2. Aumento del tamańo del hemicerebelo derecho con desplazamiento del tronco. |
 |
| Figura 3. Engrosamiento de los pliegues cerebelosos. |
 |
| Figura 4. Engrosamiento de los pliegues cerebelosos. |
 |
| Figura 5.Infiltración subaracnoidea por el linfoma. H-E x10 |
|
| Figura 6.Detalle del linfoma. Linfocitos de gran tamańo junto con figuras de apoptosis. H-E x40. |
 |
| Figura 7.Infiltración de los espacios de Virchow-Robin. H-E x10 |
 |
| Figura 8.Infiltración de pares craneales. H-E x10 |